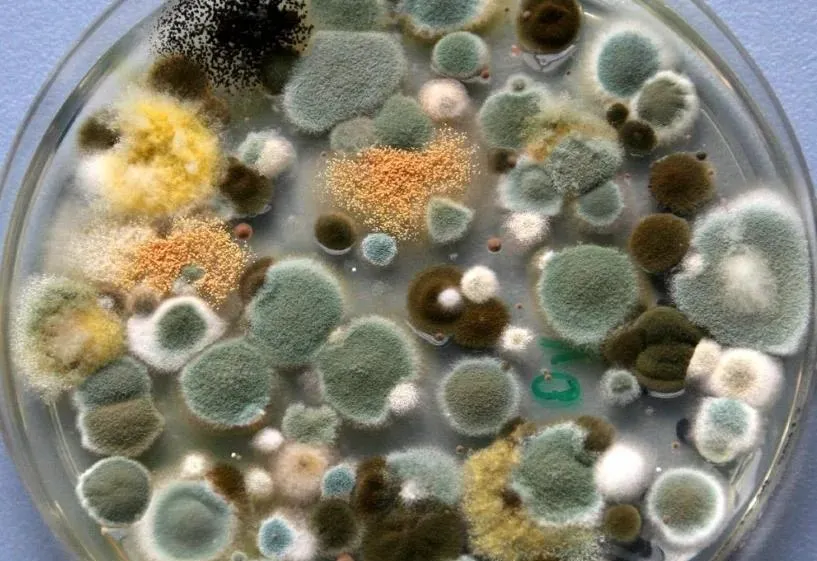

In large-scale poultry farming, mold contamination stands as one of the most vexing challenges for breeders. Many farmers report that, despite the year-round use of mold detoxifiers and regular disinfection, mold outbreaks continue to recur within their chicken farms; indeed, the problem often becomes increasingly difficult to control the more they attempt to prevent it, thereby severely compromising flock health and farming profitability.
I. In-Depth Analysis: The 4 Core Reasons Why Mold in Poultry Farms Becomes Increasingly Difficult to Control Despite Prevention Efforts
The difficulty in controlling mold in poultry farms is not attributable to a single factor; rather, it is the cumulative result of four major issues: failure to cut off sources of contamination, improper prevention and control methods, a lack of strategies tailored to the specific characteristics of the mold, and the weakened physical constitution of the chicken flock. Many poultry farmers fall into the trap of "treating without preventing" or "preventing without precision," ultimately leading to recurrent mold outbreaks that become increasingly stubborn despite their prevention efforts.
1. Concealed Sources of Contamination: Failure to Completely Sever Transmission Pathways
This constitutes the fundamental root cause behind the difficulty in controlling mold. Many livestock farmers focus solely on moldy feed while overlooking other hidden sources of contamination. Feed ingredients, for instance, may harbor "latent mold"—contamination invisible to the naked eye yet already teeming with mold spores—which, upon procurement, are fed directly to the animals, thereby becoming a primary source of mold transmission. Furthermore, biofilms within drinking water lines, residual feed at the bottom of feed troughs, floor bedding, and unremoved manure all serve as "breeding grounds" for mold proliferation. This is particularly true in high-temperature and high-humidity environments, where residual feed in troughs can turn moldy within just 4 to 6 hours; subsequently, mold spores present in the water lines are ingested by the flock along with their drinking water, creating a cycle of continuous contamination. Moreover, mold within incubators can penetrate eggshells to infect developing embryos; consequently, newly hatched chicks emerge already carrying the mold, thereby creating a latent risk of flock-wide infection right from the very source.
2. Molds possess unique characteristics, including strong drug resistance and reproductive capabilities.
Mold spores possess remarkable vitality, exhibiting high tolerance to both extreme heat and cold; in humid environments, they can germinate and proliferate rapidly. Furthermore, they are capable of spreading through various channels—including air, feed, drinking water, and farming equipment—and can disseminate throughout an entire flock or herd within a very short timeframe. Concurrently, the prolonged and exclusive use of a single type of mold control product can induce drug resistance in the mold strains. This leads to a significant decline in the efficacy of conventional treatments, resulting in a scenario characterized by "ineffective medication and recurrent mold contamination." Moreover, global warming has normalized conditions of high temperature and high humidity, thereby further elevating the germination rate of mold spores and exacerbating the persistent nature of mold contamination.
3. The chicken flock is physically weak and lacks sufficient resistance to mold.
Mycotoxins are classic immunosuppressants; they inflict persistent damage upon vital organs—such as the liver and kidneys—and compromise the intestinal mucosal barrier. This leads to a decline in the flock's immunity, thereby creating a vicious cycle characterized by "mycotoxin infection, diminished immunity, and increased susceptibility to further infection." Concurrently, the chronic misuse of antibiotics disrupts the intestinal microbiota balance—specifically by depleting beneficial bacteria—thereby creating conditions conducive to mycotoxin colonization. Furthermore, frequent immune stressors and nutritional imbalances further erode the flock's resistance to mycotoxins; consequently, even when fundamental preventive and control measures are diligently implemented, the flock remains highly susceptible to recurrent mycotoxin outbreaks.
II. Clinical Symptoms of Fungal Infections in Poultry Farms: Accurate Identification to Avoid Missed Opportunities for Prevention and Control
Following a fungal infection in a poultry farm, clinical symptoms tend to be insidious and highly variable; symptoms differ slightly among flocks of different age groups and are easily confused with common intestinal or respiratory diseases. Consequently, poultry farmers must accurately identify these signs to seize the critical window for prevention and control, thereby preventing the spread and exacerbation of the fungal infection.
1. Chicks (Most Susceptible; Most Severe Impact)
Following infection, chicks typically exhibit an acute onset of symptoms characterized by depression, ruffled and disheveled plumage, and a lowered head with a retracted neck. Feed intake declines drastically, while water consumption surges. A hallmark symptom is intractable diarrhea; the feces appear yellow-green or grayish-white, contain undigested feed residues, and emit a rancid, foul odor. Some chicks develop crop impaction and distension; manual compression of the crop causes acidic, foul-smelling fluid to regurgitate, and white pseudomembranes may be observed on the oral mucosa. In severe cases, chicks experience respiratory distress and open-mouthed breathing; the lungs and air sacs develop yellow or grayish-white fungal nodules. Death often ensues rapidly—within a short period—due to dehydration and organ damage or failure; mortality rates can range from 30% to 50%. Surviving chicks exhibit stunted growth and uneven development, resulting in "runts" (permanently stunted birds).
2. Growing Chickens
In growing chickens, infection typically follows a chronic course; birds appear listless, and their plumage becomes coarse and dull. Feed intake is reduced, growth stagnates, and body weights fail to meet target standards, while the feed conversion ratio rises significantly, thereby prolonging the time required to reach market weight. Diarrhea symptoms wax and wane, with droppings appearing loose, soft, and paste-like, often mixed with mucus or streaks of blood. Chronic diarrhea leads to anemia within the flock and pale combs; in some birds, mycotic nodules may appear on the face or forehead. The birds become highly susceptible to secondary infections—such as *E. coli* and coccidiosis—resulting in a marked increase in mortality and culling rates.

3. Laying Hens
Following infection, the most prominent manifestation in laying hens is a precipitous drop in egg production rates—ranging from 10% to 40%. Additionally, eggshell quality deteriorates, leading to an increased incidence of soft-shelled, rough-shelled, and pale-shelled eggs; the overall color of the eggshells lightens, and the duration of the peak laying period is shortened. Concurrently, the flock exhibits signs of depression and reduced feed intake, accompanied by diarrhea and ruffled feathers. Some birds develop gizzard and proventriculus inflammation, characterized by gizzard ulceration and discoloration (blackening), as well as swelling of the proventriculus. In severe cases, ascites (abdominal fluid accumulation) and hepatomegaly (enlarged liver) may occur; extreme cases may even necessitate the premature culling of affected birds, resulting in substantial economic losses for the poultry operation.

4. Symptoms of Latent Infection
In some flocks, infection presents no obvious clinical symptoms; instead, it manifests merely as slightly reduced feed intake, slowed growth, and a minor decline in egg production. However, these birds continue to excrete feces containing fungal spores, thereby becoming latent sources of infection that silently infect healthy flocks. This leads to recurrent fungal outbreaks that are difficult to completely eradicate—a primary reason why many poultry farms find fungal infections increasingly difficult to control, despite their preventive efforts.
III. Scientific Prevention: Dispelling Misconceptions in Mold Control and Eliminating Recurrence at the Source
The key to resolving the dilemma where mold in poultry farms becomes increasingly difficult to control despite preventive efforts lies in "cutting off sources, implementing scientific controls, and applying targeted strategies." By analyzing the specific transmission characteristics of mold—as well as common misconceptions regarding its control—Vitboo has formulated a set of standardized preventive measures. These measures, paired with our specialized product solutions, work to mitigate the risk of mold infection at its very root, thereby preventing recurrent outbreaks.
1. Cut Off Pollution at the Source: Minimize Mold Growth from the Root
Strictly control feed quality by selecting high-grade, mold-free raw materials; require suppliers to provide mycotoxin test reports at the time of purchase to avoid using ingredients—such as corn and soybean meal—that harbor latent mold contamination. Store feed in dry, well-ventilated, and cool warehouses, maintaining humidity levels below 65%; store feed off the ground and away from walls, adhering to the "First-In, First-Out" principle. During seasons characterized by high temperatures and humidity, procure feed in smaller, more frequent batches to prevent prolonged storage, which fosters mold growth. Concurrently, regularly clean feed troughs and drinking lines: wash drinkers and troughs daily, and flush drinking lines weekly using a high-efficacy disinfectant to eliminate biofilm and feed residues. Promptly remove chicken manure and bedding for safe, sanitary disposal to prevent the proliferation of mold spores resulting from the spoilage of waste materials; for floor-reared poultry farms, regularly replace bedding to ensure it remains dry and clean.
2. Select Control and Prevention Products Scientifically to Avoid Ineffective Measures
Move beyond reliance on single-mechanism physical mycotoxin binders; instead, opt for Vitboo Mycotoxin Binder for Chickens. Utilizing a dual mechanism of "physical adsorption + biodegradation," this product efficiently adsorbs and degrades various mycotoxins—such as aflatoxins, vomitoxins, and zearalenone—present in both feed and the surrounding environment. Simultaneously, it inhibits the growth and proliferation of mold, thereby reducing toxin production at the source. This approach avoids the common pitfall of "adsorption without sterilization," while ensuring that essential nutrients—such as vitamins and amino acids—are not inadvertently adsorbed from the feed. Furthermore, it does not impose an additional burden on the flock's liver and kidneys, making it ideally suited for long-term preventive use. During daily feeding, Vitboo Mycotoxin Binder can be paired with Vitboo Intestinal Health Additive for Chickens to regulate intestinal flora balance, repair the intestinal mucosal barrier, enhance the flock's resistance to mold, and reduce the likelihood of mold-related infections.
3. Strengthen flock constitution and enhance resistance to mold.
Provide high-quality, complete feed to ensure a balanced diet, supplementing it with essential nutrients such as vitamins, minerals, and amino acids. Strictly avoid feeding moldy feed to minimize the harm caused by mycotoxins to the flock. Periodically add Vitboo—a poultry-specific immune enhancer—to the feed to regulate the flock's immune function, repair liver and kidney damage caused by mycotoxins, and boost the birds' overall resistance. This intervention breaks the vicious cycle of "mycotoxin exposure leading to immune suppression," thereby fundamentally strengthening the flock's ability to resist mycotoxins and reducing the incidence of recurrent infections.
 IV. Highly Effective Treatment: Vitboo Exclusive Products—Comprehensively Resolving the Persistent Problem of Recurrent Fungal Infections.
IV. Highly Effective Treatment: Vitboo Exclusive Products—Comprehensively Resolving the Persistent Problem of Recurrent Fungal Infections.
Upon detecting a fungal infection within the flock, immediately isolate the affected birds and replace their feed with fresh, mold-free alternatives. Administer Vitboo—a veterinary medication specifically formulated for poultry mold infections—to the entire flock. For enhanced efficacy, use Vitboo in conjunction with the brand's mold detoxifier and intestinal health supplements to intensify mold detoxification, inhibit bacterial growth, reduce inflammation, and promote intestinal repair. During the treatment period, increase ventilation and disinfection within the poultry house; additionally, clean feed troughs and drinking lines daily, and administer electrolytes and multivitamins to alleviate stress. Continue this regimen for 3 to 7 consecutive days. Clinical trials conducted at poultry farms across various global regions have demonstrated that, following the use of Vitboo products, the cure rate for fungal infections in flocks exceeds 95%, while chick mortality rates drop to below 5%. Furthermore, the products effectively prevent recurrent mold outbreaks, enabling poultry farmers to definitively resolve the persistent dilemma where "mold becomes increasingly difficult to control despite preventive efforts," thereby minimizing economic losses and rapidly restoring the flock's health and productive performance.
V. Vitboo: Focusing on Poultry Health, Solving the Core Pain Points of Chicken Farming
The more poultry farms attempt to prevent mold contamination, the more difficult it often becomes to control. The root causes typically lie in a failure to accurately identify the source of the problem, the use of inappropriate control methods, and a lack of product suitability. As a specialized enterprise dedicated to the R&D and export of veterinary pharmaceuticals and feed additives, Vitboo remains steadfast in its philosophy of "safeguarding livestock health and empowering efficient farming." By deeply focusing on the field of mold prevention and control in poultry farms—and drawing upon global expertise in this domain—we continuously iterate and upgrade our product formulations. Our product series—including mycotoxin binders, specialized anti-mold veterinary medicines, and intestinal health additives—leverage advantages such as high efficacy, safety, and user-friendliness to help poultry farmers effectively and permanently resolve the persistent challenges associated with mold control.
Mycoplasma Synoviae Outbreaks Surge: New Symptoms Emerge in African Poultry Farms
2026-07-07Summer Mosquito Infestation in Africa: Alert for Swine Japanese Encephalitis Outbreaks
2026-07-01Sores on your sheep's mouth? Watch out for Contagious Pustular Dermatitis.
2026-04-13Do you truly understand the dangers of necrotic enteritis in poultry?
2026-01-14The most common bacterial disease in poultry—E. coli infection
2026-01-06What is Newcastle disease (ND) and How to Prevent and Treat of New Castle (ND)?
2024-12-17Phone:+86 135 9888 1411
Tel:+86-0371-88959050
Email:sales@vitboo.com
Address:Zhengzhou City, Henan Province, China